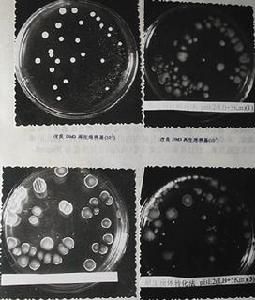
硝化螺旋菌門 硝化螺旋菌門

基本信息
硝化菌對水生植物非常重要,在水體中,如果缺少硝化菌,氨氮/硝酸鹽/亞硝酸鹽循環體系被中斷,將導致水生環境破壞和魚類的死亡。而硝化螺旋菌門(Nitrospira)是存在於污水處理廠和實驗室反應器中主要的亞硝酸氧化菌,而不是Nitrobactor。
參考
硝化螺旋菌門是一個與細菌相關的小作品。你可以通過編輯或修訂擴充其內容。
•1 酸桿菌門(Acidobacteria)
•2 放線菌門(Actinobacteria)
•3 產水菌門(Aquificae)
•4 擬桿菌門(Bacteroidetes)
•5 衣原體門(Chlamydiae)
•6 綠菌門(Chlorobi)
•7 綠彎菌門(Chloroflexi)
•8 產金菌門(Chrysiogenetes)
•9 藍藻門(Cyanobacteria)
•10 脫鐵桿菌門(Deferribacteres)
•11 異常球菌-棲熱菌門(Deinococcus-Thermus)
•12 網團菌門(Dictyoglomi)
•13 纖維桿菌門(Fibrobacteres)
•14 厚壁菌門(Firmicutes)
•15 梭桿菌門(Fusobacteria)
•16 芽單胞菌門(Gemmatimonadetes)
•17 黏膠球形菌門(Lentisphaerae)
•18 硝化螺旋菌門(Nitrospirae)
•19 浮黴菌門(Planctomycetes)
•20 變形菌門(Proteobacteria)
•21 螺旋體門(Spirochaetes)
•22 熱脫硫桿菌門(Thermodesulfobacteria)
•23 熱微菌門(Thermomicrobia)
•24 熱袍菌門(Thermotogae)
•25 疣微菌門(Verrucomicrobia)
•26 門未定